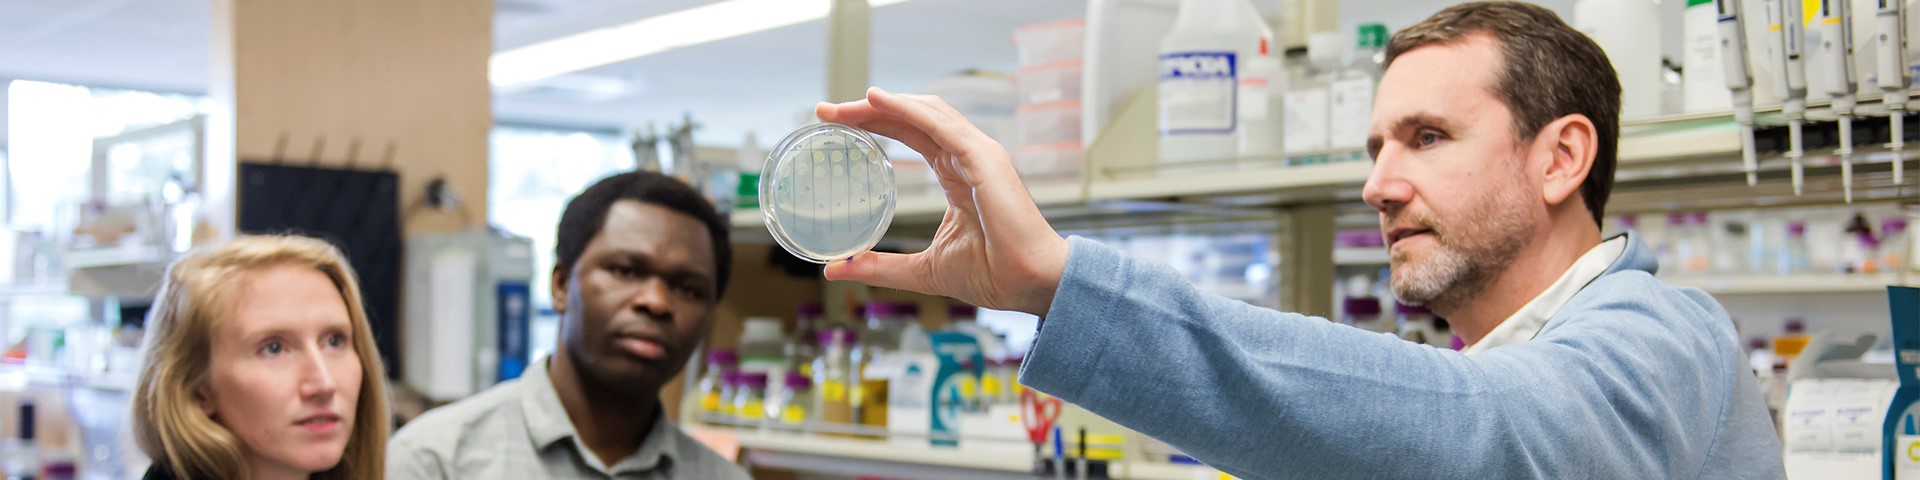

Interdisciplinary Training Opportunities
There are a number of additional opportunities for graduate students to enhance their training. OHSU has several NIH training grants (T32) and the Career & Professional Development Center can help identify potential internships or externships.
The following NIH T32s provide additional training opportunities for students in PBMS:
-
Students will enter the Program in Enhanced Research Training (PERT) in their second year of graduate training through a competitive application process. PERT trainees will spend one year in intensive training through courses and activities that emphasize the competencies they will need to develop a successful career in biomedical research. PERT students will commit to continued involvement in PERT through a Peer-to-Peer Mentoring program up through year 5 of their graduate training. This will provide PERT trainees with continuous training in communication, leadership, management, teamwork, and continued exposure to diverse research fields as they interact with the growing cohort of current and former PERT trainees.
Program details
Progress in Research Meetings
PERT trainees will meet bi-monthly for one hour (6 hours per year) with the Program Director and the Peer-to-Peer Mentoring group for evaluation of progress in research. PERT trainees will each give two 10 minute oral presentations during the course of the training period. The presentations will be critiqued by the PD, fellow PERT trainees and the Peer-to-Peer Mentoring cohort using a standardized evaluation process. The entire group will provide troubleshooting advice and helpful suggestions on refinement of hypotheses, development of specific aims, experimental design and data analysis. This will provide the foundation for the development of an individual research proposal, which will be woven into these meetings. Trainees will be expected to use this opportunity to begin constructing their proposal and obtaining feedback throughout the course of the year. Dissertation mentors will be encouraged to attend their trainees’ presentations.
Topics in career development
This series will occur four times per year, alternating with the Progress in Research meetings. Topics for specific meetings will be adapted to the needs and interests of the trainees.
- Navigating your mentor relationship and selecting your dissertation advisory committee
- Time management
- Effective scientific communication
- Writing your thesis and how grant proposals are evaluated
- Building your professional network
- Choosing and landing a post-doctoral fellowship
Curriculum overview
In addition to the standard PBMS curriculum, PERT students are required to take the following additional courses and unique training activities designed specifically to meet the goals of PERT. These courses and activities include:
- Data Rigor and Reproducibility (CONJ 610N, 0.5 credits; Summer term)
- Molecular and Cellular Approaches to Disease (HIP 514, 2 credits; Fall term)
- Biostatistics for Basic Sciences (CONJ 620, 3 credits; Winter term)
- Training in Professional Science Writing Course (Spring term)
- Oral presentation at OHSU Research Week (Spring term)
- Attend quarterly Computational Biology Data Jamborees
- Progress in Research monthly meetings with the Program Director and Peer-to-Peer Mentoring Cohort
- Topics in Career Development
- Attend two IDP career development meetings (beginning and end of the training period) with Dr. Jackie Wirz, the Director of Professional Development and Graduate Student Affairs.
- Participation in one national level research conference selected by the student in consultation with their dissertation advisor, and approved by the PERT director
- Post Qualifying Exam submission of an Individual NRSA proposal (or equivalent fellowship) by the nearest deadline for the specific fellowship opportunity.
- Commitment to actively participate in the PERT Peer-to-Peer Mentoring Program through year 5 of graduate training.
Application process
In the Spring, a request for applications will be distributed to first-year PBMS students who matriculated in the previous Fall Term. Applications will be reviewed by an ad-hoc selection committee composed of PERT faculty members. Evaluation of applications will give significant weight to the following criteria:
- Quality of the research plan
- Previous preparation of the applicant, including courses taken, grades received, and scientific work accomplished and/or published.
- Letters of recommendation
- The commitment of the training grant to support underrepresented minorities, disabled individuals, and women.
- The commitment of the training grant to achieve a reasonable distribution of awards over the laboratories of different preceptors that participate in PBMS.
-
The objective of this program is to prepare trainees in the fundamentals of vision science research, and to provide mentoring to enable trainees to become independent vision researchers. Learn More.
-
Prof. Beth Habecker has been awarded funding from NIGMS to support the new OHSU Chemical Physiology T32 fellowship program. The goal of the OHSU Chemical Physiology T32 program is to produce a new generation of scientists who will elucidate the fundamental mechanisms that undergird health and disease by applying chemical biology tools to understand physiology, pathophysiology, and medicine. A unique aspect of this training program is that students will receive training in both chemistry and physiology in a medical school environment. Profs. Kimberly Beatty and Michael Cohen will serve as Associate Directors for this program.